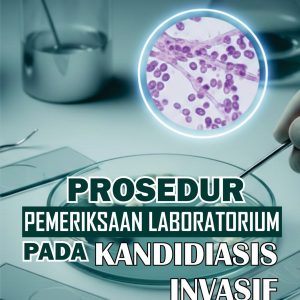
Prosedur Pemeriksaan Laboratorium pada Kandidiasis Invasif

BUKU NON FIKSI
Showing 1–15 of 849 resultsSorted by latest
-
BUKU NON FIKSI
Prosedur Pemeriksaan Laboratorium untuk Mendeteksi Haemophilus influenzae
Rp54.000,00 Add to cart -
BUKU NON FIKSI
Program Gizi Ibu dan Anak: Konsep, Implementasi, dan Evaluasi
Rp94.000,00 Add to cart -
BUKU NON FIKSI
Sosiologi Pertanian: Dinamika Sosial, Inovasi, dan Keadilan Pangan di Era Modern
Rp123.000,00 Add to cart